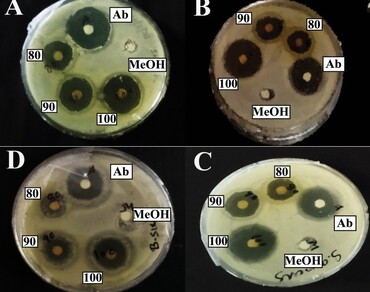
Antibacterial activity and GC–MS profiling of Stephania glandulifera Miers root extract

Vol 38 Issue 6, December 2025
Total Articles: 42

Profiling of aroma volatile compounds and antimicrobial potentiality of two Blumea species: A comparative insight of experimental and computational studies
Research Articles
Views: 1784
Pages: 2403-2416
Published: 15 October, 2024
Doi: 10.1007/s42535-024-01040-w

Light spectra on in vitro seed germination of the Brazilian cactus Cereus jamacaru DC. subsp. jamacaru
Research Articles
Views: 1797
Pages: 2417-2424
Published: 21 October, 2024
Doi: 10.1007/s42535-024-01061-5

Optimizing antioxidant potential and mitigating antinutritional factors in pearl millet (Pennisetum glaucum) via fermentation with Lactobacillus reuteri
Research Articles
Views: 1790
Pages: 2425-2436
Published: 23 October, 2024
Doi: 10.1007/s42535-024-01057-1
Antibacterial activity and GC–MS profiling of Stephania glandulifera Miers root extract
Research Articles
Views: 2218
Pages: 2437-2446
Published: 23 October, 2024
Doi: 10.1007/s42535-024-01069-x

Synergistic microbial consortia for lignocellulose decomposition in paddy straw
Research Articles
Views: 812
Pages: 2447-2452
Published: 28 October, 2024
Doi: 10.1007/s42535-024-01063-3

Phytochemical profile and GC–MS analysis from different parts of Terminalia chebula Retz. and Terminalia bellirica (Gaertn.) Roxb
Research Articles
Views: 2363
Pages: 2453-2461
Published: 06 November, 2024
Doi: 10.1007/s42535-024-01080-2

Physical and chemical characterization of fruits from autochthonous accessions of umbu trees (Spondias tuberosa Arr. Cam.) of the Brazilian Northeast region
Research Articles
Views: 1981
Pages: 2462-2470
Published: 06 November, 2024
Doi: 10.1007/s42535-024-01075-z

Bridging gaps: A holistic approach to conservation and propagation of Artemisia amygdalina Decne. In the face of climate change and human influence
Research Articles
Views: 1765
Pages: 2471-2481
Published: 07 November, 2024
Doi: 10.1007/s42535-024-01089-7

Inhibitory effect of Eucalyptus globulus essential oil against Botryosphaeria dothidea and Fomitiporia mediterranea fungi causing wood diseases in viticulture
Research Articles
Views: 1747
Pages: 2482-2490
Published: 10 November, 2024
Doi: 10.1007/s42535-024-01081-1